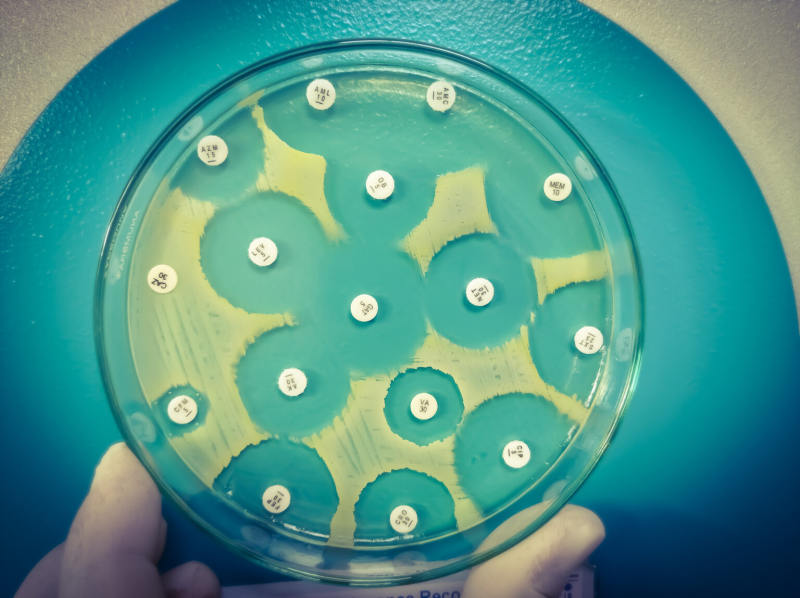

日本北海道大学市川聪教授领导的团队最近在《自然·通讯》杂志上发表论文,详细介绍了一种高效抗菌化合物的开发,该化合物可有效对抗最常见的多重耐药细菌。
抗生素是治疗多种细菌性疾病的重要药物,但由于持续过度使用和误用,耐药性细菌也在不断增加。研究团队一直致力于新型抗菌药物的开发。最近,他们合成了一种类似球霉素(sphaerimicin)的抗菌化合物,这些化合物能阻断细菌中MraY蛋白质的功能。MraY是细菌复制所必需的,在细菌细胞壁的合成中发挥作用,但并未成为目前商业抗生素的目标。
研究人员表示,生物化合物球霉素具有非常复杂的结构,他们着手设计了这种分子的类似物,它更容易制造,同时对MraY更有效,从而提高了其抗菌活性。新设计的药物可有效对抗耐甲氧西林金黄色葡萄球菌(MRSA)和耐万古霉素粪肠球菌(VRE),这是两种很常见的多重耐药细菌。
该团队通过分子建模辅助计算分析了球霉素A的结构,设计合成了球霉素A的两个类似物SPM1和SPM2。研究发现,这些类似物对革兰氏阳性细菌有效。
然后他们确定了与MraY结合的SPM1的结构。通过研究这种结构并将其与相关抗菌剂的结构比较,他们进一步简化分子,成功开发了一种更简单的类似物SPM3,其活性与SPM1相似。
除了对MRSA和VRE有效外,SPM对结核分枝杆菌也有效,结核分枝杆菌是导致结核病的细菌,并且具有多重耐药菌株。
团队成员总结道,新研究最重要的贡献是球霉素核心骨架的构建,它可用于开发更多靶向MraY的抗菌剂,从而开发出针对更多耐药菌株的药物。球霉素是最有前途的,因为MraY也存在于革兰氏阴性细菌中。未来的工作将包括优化目前开发的SPM分子,以及开发含球霉素的抗生素组合以针对更广泛的细菌。
版权声明:除特殊说明外,本站所有文章均为 字节点击 原创内容,采用 BY-NC-SA 知识共享协议。原文链接:https://byteclicks.com/44523.html 转载时请以链接形式标明本文地址。转载本站内容不得用于任何商业目的。本站转载内容版权归原作者所有,文章内容仅代表作者独立观点,不代表字节点击立场。报道中出现的商标、图像版权及专利和其他版权所有的信息属于其合法持有人,只供传递信息之用,非商务用途。如有侵权,请联系 gavin@byteclicks.com。我们将协调给予处理。
赞
